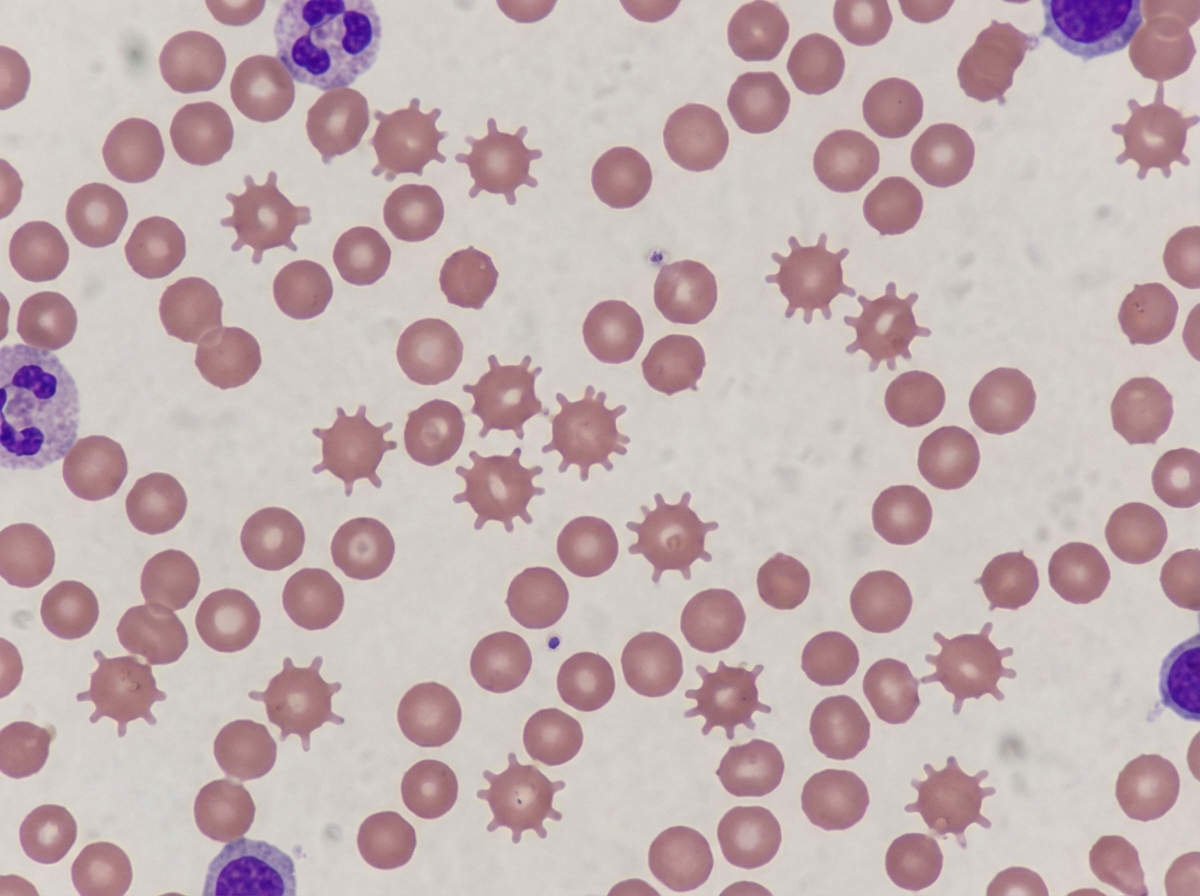
Image for question 314

Which of the following hematological malignancies is responsible for the finding shown in the image?

Which type of anemia is caused by iron deficiency?
A patient of multiple myeloma presents with bony lesions. What is the best prognostic marker for the disease?
These types of RBCs are seen in which condition?
A patient has a deficiency of Von Willebrand factor. Which of the following abnormalities are seen in this patient?
In Promyelocytic Leukemia, which of the following is NOT a typical feature?
Which type of cell constitutes the largest population in the bone marrow?
ABO antigens are not seen in which of the following?
Diagnostic criteria of pure red cell aplasia (PRCA) includes all of the following, except:
Fanconi's anemia is classified as which of the following types of anemia?
Anemias: Classification and Approach
Practice Questions
Hemolytic Anemias
Practice Questions
Myeloproliferative Neoplasms
Practice Questions
Myelodysplastic Syndromes
Practice Questions
Acute Leukemias
Practice Questions
Chronic Leukemias
Practice Questions
Lymphomas and Lymphoid Neoplasms
Practice Questions
Plasma Cell Disorders
Practice Questions
Bleeding Disorders
Practice Questions
Thrombotic Disorders
Practice Questions
Get full access to all questions, explanations, and performance tracking.
Scan to download app